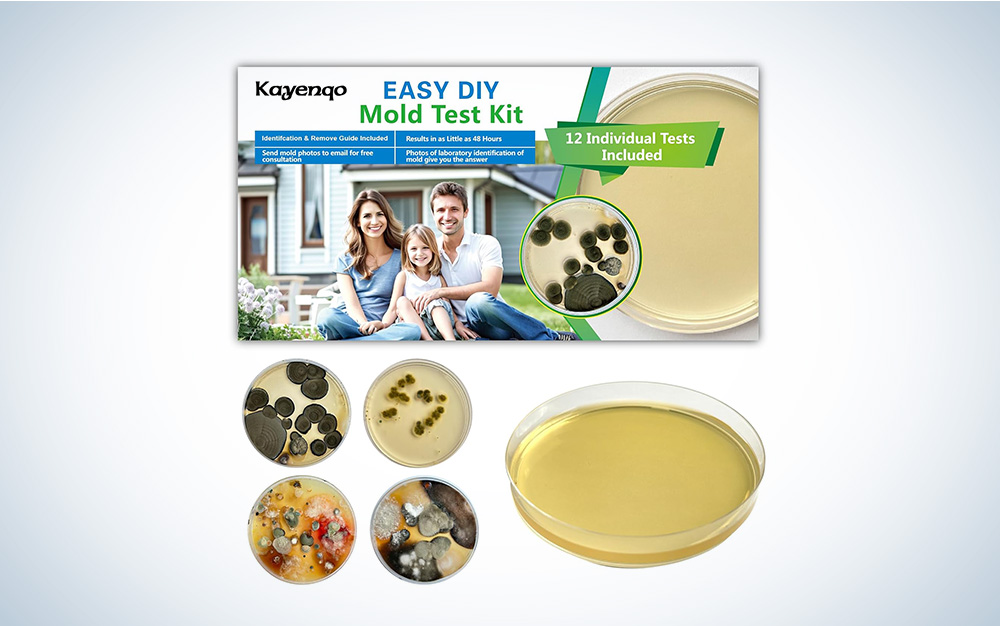
Mold tests shown against a grey gradient

We may earn revenue from the products available on this page and participate in affiliate programs. Learn more ›
Indoor air can be three to five times more polluted than outdoor air, according to the U.S. Environmental Protection Agency, which also notes that most people spend 90 percent of their time indoors. Fortunately, you can test your indoor quality by yourself and with the help of a professional to determine if you have a problem. And in a world of increasing wildfires and invisible irritants, we’d recommend it. We at PopSci always want to ensure we’re giving you the best advice, so we consulted with a team of experts to explain why and how to measure air quality and take steps to correct it in your home.
“The average person breathes 20,000 breaths per day—yet air quality is typically the last thing we think of, if at all, when it comes to ongoing wellness,” says Michael Rubino, mold and air-quality expert, environmental wellness advocate, and founder of HomeCleanse. He also hosts the “Never Been Sicker” podcast and is chair of Change the Air Foundation.
Rubino explains that our air plays a significant role in our ongoing wellness. “If the air is filled with VOCs, mold, bacteria, allergens, pesticides, lead, or a number of other things, that will negatively impact our health,” he says.
And although modernization has resulted in more efficient buildings, Rubino says modern construction practices have contributed to lowering indoor air quality. “The increasing focus on achieving net-zero energy efficiency has led to the creation of buildings that are more tightly sealed, with limited airflow between the indoors and outdoors.” And combining this limited air flow with the proliferation of manmade contaminants (like VOCs and pesticides) creates the perfect storm for a hazardous environment.
Some of the really nasty stuff in your indoor air can include Benzene, Xylene, and Mycotoxins. “Benzene, a substance naturally present in crude oil, gasoline, and cigarette smoke, is widely used in manufacturing plastics, resins, synthetic fibers, and many other products such as lubricants, rubbers, dyes, and pesticides,” Rubino says. Exposure can cause neurological issues, immune system damage, headaches, and even cancer.
As for Xylene, it “is often introduced through products like paint thinners, solvents, and lacquers—and exposure to this chemical can result in nausea, dizziness, neurological effects, and more,” Rubino adds.

Mycotoxins are a byproduct of mold. “Two common household mycotoxins are Aflatoxins and Ochratoxin A—and exposure to Aflatoxins can result in nausea, vomiting, abdominal pain, convulsions, and increased risk of liver cancer,” Rubin explains. Ochratoxin is a carcinogen, and he says it can suppress the immune system and has been linked to chronic kidney disease.
Need another reason to test your indoor air quality? “Researchers observed that the lungs of nonsmokers in their study contained blackened nodes when they should have appeared beige and, upon further analysis, they found that these black particles came from airborne pollutants, which impaired the lungs’ ability to defend the body against harmful pathogens, leading to an increased risk of respiratory illnesses,” Rubino says.
How to test your home’s indoor air quality yourself
According to Brad Roberson, president of Aire Serv, a Neighborly company, you can get a sense of your home’s air quality by checking for common warning signs. “These include persistent musty, moldy or mildew odors and dust buildup on or near vents,” Robertson says, adding that frequent sneezing, coughing or headaches can also indicate air-quality issues.
“Homeowners can also use a hygrometer to ensure humidity levels are between 30 and 50 percent, since dry or irritated sinus cavities, nose bleeds, buckling floorboards, or damage/warping of wood furniture can be signs of low humidity levels.”
Dreo Cool Mist Humidifier
The Dreo Cool Mist Humidifier has a hygrometer that measures humidity levels. The ultrasonic top-fill humidifier can be used in every room from the nursery to the master bedroom.
If you have organic growth—like mold and mildew—throughout the home, around vents, ductwork, or HVAC equipment, Roberson says this can signal high humidity levels. “These can all be controlled with whole-home humidification and dehumidification systems,” Roberson explains.
Home test kits for specific contaminants
Lisa Sternfeld, interior designer, environmental health and wellness expert, and founder of WLLW, recommends starting with affordable at-home testing kits for common pollutants.
Allergen testing
Sternfeld advises using at-home kits that detect allergens like dust mites, pet dander, and pollen, as they can provide valuable insight into airborne irritants you can then mitigate.
Mold testing
“Mold exposure can trigger a host of health issues, and home kits for mold spores help you identify if your living space is harboring hidden growth,” Sternfeld says.
Mold Test Kit For Home
This Mold Test Kit for Home lets you test in three different ways. You can test the air in a room or on a physical surface, or you can test your HVAC system.
VOC testing
“Volatile organic compounds [such as formaldehyde and benzene] often off-gas from household products and materials,” Sternfeld explains. She says VOC testing kits can help you determine if these are present in high concentrations in your indoor air.
Simple air-quality monitors
For broader monitoring, Sternfeld recommends handheld or portable air-quality monitors. “They can track particulate matter [PM2.5] like pollen and smoke particles from cooking, carbon dioxide [CO2], and VOCs, which are common pollutants from paint, furniture, and cleaning products.”
Temtop M2000 2nd Generation
As a bonus, these devices provide real-time data, and Sternfeld says this allows you to adjust airflow or filtration as needed.
Smart air purifiers, like those on our list of the best air purifiers for asthma, include real-time monitoring.
Levoit EverestAir Smart Air Purifier
The Levoit EverestAir Smart Air Purifier can monitor and capture everything from dust to pollen and other allergens. When the auto feature is engaged, it automatically detects the air-quality level and adjusts accordingly. Air-quality indicator rings turn colors to indicate when the air quality is good, fair, and poor.
Roberson agrees, noting the consumer-level indoor air-quality monitors can be used to track VOC levels from common sources like cleaners, paint, or furniture—and also track CO2 levels, temperature, and humidity. “The monitors provide a helpful overview but are not as precise or in-depth as professional equipment,” he says.
Airthings 360 View Plus Air-Quality Monitor
The Airthings 360 View Plus Air-Quality Monitor can monitor radon, VOCs, particulate matter, CO2, humidity, temperature, and more. The wireless monitor can be mounted on the wall or set on a table, and the app lets you view real-time data remotely.
How a professional tests your indoor air quality
Rubino provides bulleted lists on what the professionals test for and what they use, compared to the tools available directly to consumers.
What professionals test for
- Particulate Matter (PM1, PM2.5, PM10) – fine particles that can affect lungs
- Volatile Organic Compounds (VOCs) – off-gassed chemicals from furniture, cleaners, etc.
- Formaldehyde – a common VOC from building materials
- Mold Spores and Mycotoxins – biological contaminants that impact immune system health
- Carbon Monoxide (CO) & Carbon Dioxide (CO₂) – for combustion safety and ventilation
- Humidity & Temperature – for mold and bacteria prevention
- Radon Gas – especially in basements and ground-level homes
- Bacteria & Actinobacteria – microbial contamination from water damage
- Airborne allergens – pollen, pet dander, and dust mites
What professionals use
- Laser Particle Counters – for measuring PM levels in real time
- VOC Detectors – using photoionization detection (PID) or flame ionization detection (FID)
- Formaldehyde Detectors – calibrated to industry standards
- Petri dish (agar), Surface Sampling, Air Sampling, and The Dust Test – analyzed in a lab for mold
- Thermal Imaging Cameras – to identify hidden moisture problems
- Borescopes & Moisture Meters – for inspecting inside walls and under floors
- Radon Test Kits (Continuous Monitors or Alpha Track) – for long-term exposure
- CO/CO₂ Monitors – to assess combustion safety and air exchange
- Lab Analysis – many samples are sent to accredited labs (e.g., for mold, mycotoxins, VOCs)
How that is different from DIY
“A professional IAQ [indoor air quality] assessment provides a deeper, science-backed look into what’s floating around your home, often with lab testing and pinpointed recommendations,” Rubino says. “It’s ideal if someone isn’t feeling well and they’re assessing their environment as a possible culprit, or if there was a recent event that allows contaminants to thrive—like water damage.”
On the other hand, Rubino explains that a homeowner assessment is more about monitoring trends and maintaining general air quality. He says this is useful for everyday awareness, but lacks the precision or depth to identify specific sources. “This would be a ‘Do I have a problem’ step before bringing in a professional to determine the extent of the situation,” Rubino says.
According to Roberson, an IAQ professional (including an HVAC professional) can better determine the home’s indoor air quality and how to improve it with professional-grade equipment. “For example, HVAC professionals can perform HVAC inspections, checking for issues affecting airflow and cleanliness, and also recommend actionable solutions, such as whole-home purification with equipment like electronic air cleaners, UV-C light purifiers, and activated carbon filters.”